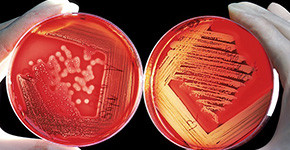
Schimmel analysieren

Was tun bei Schimmelbefall?
Verfallen Sie nicht in Panik. Bewahren Sie Ruhe. Gehen Sie logisch vor (Tipps und Anleitung).
Zu Schimmelbildung kann es durch mehrere Ursachen kommen, durch falsches Lüften, falscher Möblierung, unterschiedlich geheizten Räumen oder entstanden durch einen Wasserschaden. Die Ursache hierzu muss zumindest grob festgestellt und kategorisiert werden. Wenden Sie sich anschließend an unser kompetentes Team. Schimmelanalyse und -bekämpfung macht erst Sinn, wenn die Ursache behoben ist.
Schimmelpilz
Der Begriff Schimmelpilz wird in der Mykologie als Unterbegriffsbezeichnung einer Gruppe von filamentösen (Ausprägung von Fäden/Geflecht) Pilzen verwendet. Man findet derartige Ausprägungen immer in farbiger Darstellung auf unterschiedlichsten Untegründen.
Schimmel die weitverbreitete Hauptproblematik in vielen Haushalten.
Hervorgerufen, zumeist durch die permanent dichter werdende Bauweise (Siehe EnEV 2014).
Entstehender Schimmel – Hauptbestandteil sind Feuchtigkeit, Temperatur und Einwirkdauer:
|
Als Lösungsansatz wird zu Lüftungsanlagen mit WRG (nutzerunabhängige Zu- und Abluftanlagen) verwiesen, die je nach Feuchtigkeit oder CO2 Gehalt im Innenraum den Luftaustausch steuern. Derartiger Lüftungsanlagen bringen jedoch vermehrt Probleme mit sich. Sie verteilen Keime und beeinflussen somit das Wohnklima wesentlich. Es entstehen gesundheitsgefährdende Hygieneschwachpunkte. Automatisierte Be- und Entlüfungssysteme sollten daher ständig auf ihre Reinheit überprüft werden.
Schimmelpilze und Bakterien befinden sich überall in der Umwelt. Zu bestimmten Jahreszeiten (Herbst) finden sich tausende Schimmelpilzsporen in der Außenluft. Durch notwendige Lüftungsvorgänge gelangen diese in die Wohnung und legen sich an diversen Oberflächen (wie Mauerwerk, etc.) ab. Wird nicht gelüftet, können sich die sogenannten Hypen durch Feuchtigkeitseinwirkung (konstant über 70% rel. Luftfeuchte) zu Mycelen und in später Folge zu sichtbarem Schimmelpilz ausprägen.
Wie kommt Feuchtigkeit in die Raumluft?
- Jede Person - produziert 1 bis 1,5 Liter/Tag
- Pflanzen - 0,5 - 1 Liter/Tag
- Aquarium - 0,5 - 1 Liter/Tag
- Wäsche - bis 1,5 Liter/Tag
- Kochen - bis 1 Liter/Tag
- Duschen - 0,5 - 1 Liter/Tag
Entscheidend ist daher das klimatische Verhältnis der Feuchtigkeitsbilanz im Innenraum. Feuchtigkeit wird durch Duschen, Baden, Kochen, Geschirrspülen und Wäsche trocknen produziert. Dies beudetet, dass zugeführte Feuchtigkeit auch wieder abtransportiert werden muss. Die Feuchtigkeit kann durch permanente Lüftungsvorgänge gesenkt werden oder auf eine komfortablere Variante gesenkt werden.
Bautrockner/Luftentfeuchter bieten hierzu eine automatisierte und komfortable Anpassung Ihres Wohnklimas.
Kategorisierung Schimmelpilz
Sichtbarer Schimmel muss anstandslos entfernt werden! Dies bedeutet, dass Desinfektion alleine zu wenig ist. Auch abgetötete Sporen und Ausbildungen können folglich noch Alergien auslösen.
Dabei spielen mehrere Faktoren eine wichtige Rolle:
Das menschliche Immunsystem ist grundsätzlich sehr Widerstandsfähig. Kommt es jedoch vermehrt zu einem intensiven Kontakt mit toxischen Schimmelpilzen, kann dies gesundheitsgefährdende Auswirkungen auf den Körper haben. Man spricht immer von der Intensität, Einwirkdauer und des Zustandes vom Immunsystem (Vorerkrankungen).
Das biologische und das optische "unschädlich" machen von Pilzgeflächten. Dies bedeutet, dass ein Schimmelpilz grundsätzlich in seiner weiteren Ausprägung gehindert (Zellstruktur/Stoffwechsel; Befallausbreitung; Sporenbildung) werden muss.
Allgemeine Chemikalien (gerne von Fachfirmen verwendet) töten den Schimmelpilz nicht zur gänze ab, sondern behandeln nur oberflächlich. Sicher Pilztötend wirken hingegen Stoffe wie Alkohol (>= 70vol%, bei feuchtem Untergrund min. 80 vol%), Wasserstoffperoxid, Chlordioxid (jedoch Gefährlich da Chlorgasbildung möglich), bei kleinen Flächen durch starkes erhitzen (Viele Pilzarten nur bis 50°C bestandsfähig), durch eine Mikrowellentechnik (Tötung der Sporen und Ausbildungen im Holz-inneren) oder Langzeitfungizide.
Kleinere Flächen bis 0,5 m² können eingenständig durch Personen mit genannte Mittel (wie Alkohol oder Wasserstoffperoxid) abgetötet werden.
Die Schimmelausprägung selbst wird in 3 Stufen unterteilt:
Die Kategorien 0-1 können selbst bzw. eigenständig behandelt werden.
Die Kategorien 2-3 dürfen nur von Fachfirmen behandelt werden.
Es rät sich jedoch immer, ein Fachpersonal zu beauftragen.
Stufe 0
- Ersichtlich
- bis 100 cm² Größe
- an einer Stelle
- in einem Raum
- Stockflecken
- Gesundheitlich und bauphysikalisch unproblematisch
Stufe 1
- Stockflecken
- bis 0,5 m² vereinzelt
- bis 100 cm² dicht
- kein Wasserschadenproblem
- Gesundheitsvorsorgetechnisch kritisch zu betrachten
Stufe 2
- über 0,5 m² vereinzelt
- über 100 cm² dicht
- Schimmel tieferschichtig
- Schimmel oder Stockflecken an mehreren Stellen
- Schimmelgeruch
- Gesundheitsvorsorgetechnisch inakzeptabel und rascher Handlungsbedarf
Stufe 3
- über 10 m² vereinzelt
- über 2 m² dicht
- Solange Pilz nicht bekannt AKUTE Gesundheitsgefähr-dung
- Keine Raumbenutzung mehr
